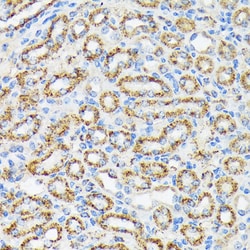
Invitrogen NDUFS4 Recombinant Rabbit Monoclonal Antibody (6T10F4) 100 &mu;L;

missing translation for 'onlineSavingsMsg'
Learn More
Learn More
Invitrogen™ NDUFS4 Recombinant Rabbit Monoclonal Antibody (6T10F4)


Rabbit Recombinant Monoclonal Antibody
Brand: Invitrogen™ MA538178
This item is not returnable.
View return policy
Description
Positive Samples: Mouse liver, Mouse heart, Rat brain, Rat kidney, Rat heart, HepG2 Immunogen sequence: MAAVSMSVVL RQTLWRRRAV AVAALSVSRV PTRSLRTSTW RLAQDQTQDT QLITVDEKLD ITTLTGVPEE HIKTRKVRIF VPARNNMQSG VNNTKKWKME.
This gene encodes an accessory subunit of the mitochondrial membrane respiratory chain NADH dehydrogenase (Complex I), or NADH:ubiquinone oxidoreductase, the first multi-subunit enzyme complex of the mitochondrial respiratory chain. Complex I plays a vital role in cellular ATP production, the primary source of energy for many crucial processes in living cells. It removes electrons from NADH and passes them by a series of different protein-coupled redox centers to the electron acceptor ubiquinone. In well-coupled mitochondria, the electron flux leads to ATP generation via the building of a proton gradient across the inner membrane. Complex I is composed of at least 41 subunits, of which 7 are encoded by the mitochondrial genome and the remainder by nuclear genes.
Specifications
| NDUFS4 | |
| Recombinant Monoclonal | |
| 1.37 mg/mL | |
| PBS with 0.05% BSA, 50% glycerol and 0.02% sodium azide; pH 7.3 | |
| O43181, Q5XIF3, Q9CXZ1 | |
| NDUFS4 | |
| Recombinant fusion protein containing a sequence corresponding to amino acids 1-100 of human NDUFS4 (O43181). | |
| 100 μL | |
| Primary | |
| Human, Mouse, Rat | |
| Antibody | |
| IgG |
| ELISA, Immunohistochemistry (Paraffin), Western Blot, Immunocytochemistry | |
| 6T10F4 | |
| Unconjugated | |
| NDUFS4 | |
| 6720411N02Rik; AQDQ; C1-18k; CI-18; CI-18 kDa; CI-AQDQ; complex I 18kDa subunit; complex I-18 kDa; Complex I-AQDQ; mitochondrial respiratory chain complex I (18-KD subunit); NADH dehydrogenase (ubiquinone) Fe-S protein 4; NADH dehydrogenase (ubiquinone) Fe-S protein 4, 18kDa (NADH-coenzyme Q reductase); NADH dehydrogenase [ubiquinone] iron-sulfur protein 4, mitochondrial; NADH:ubiquinone oxidoreductase subunit S4; NADH-ubiquinone oxidoreductase 18 kDa subunit; NDUFS4 | |
| Rabbit | |
| Affinity Chromatography | |
| RUO | |
| 17993, 4724, 499529 | |
| -20°C, Avoid Freeze/Thaw Cycles | |
| Liquid |
Product Content Correction
Your input is important to us. Please complete this form to provide feedback related to the content on this product.
Product Title
Spot an opportunity for improvement?Share a Content Correction